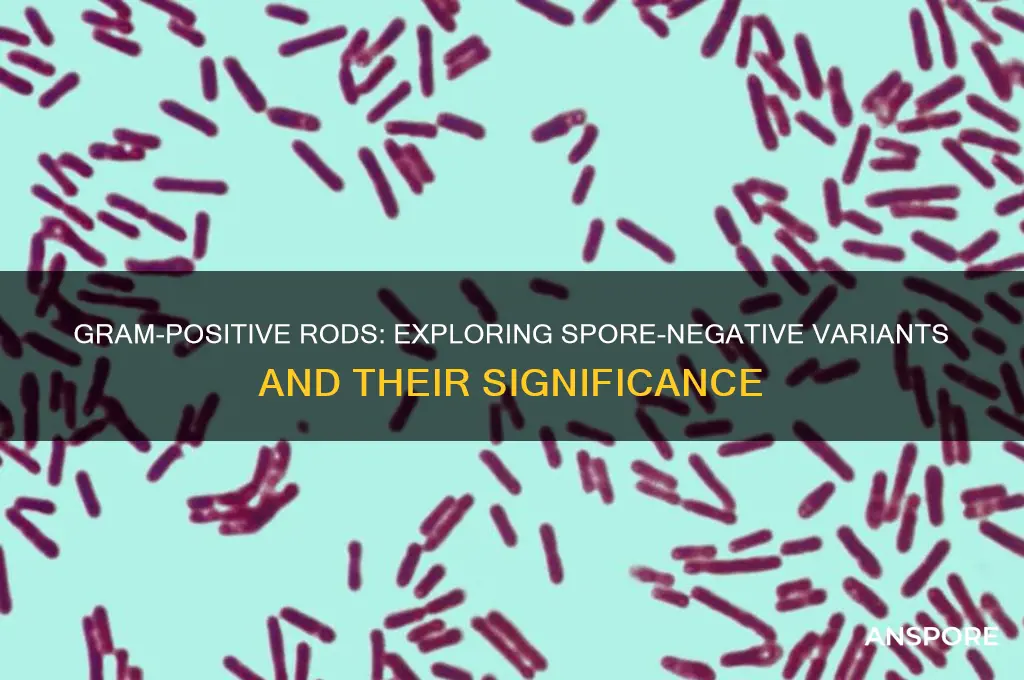
can gram positive rod also be spore negative

The question of whether Gram-positive rods can also be spore-negative is a nuanced one, as it delves into the diverse characteristics of bacterial classification. Gram-positive rods, such as *Bacillus* and *Clostridium*, are typically known for their ability to form endospores, a highly resistant dormant structure that aids in survival under harsh conditions. However, not all Gram-positive rods possess this trait. For instance, genera like *Listeria* and *Corynebacterium* are Gram-positive rods that are spore-negative, lacking the ability to form endospores. This distinction highlights the variability within bacterial groups and underscores the importance of considering multiple phenotypic and genotypic traits when classifying microorganisms. Understanding this diversity is crucial for accurate identification, clinical diagnosis, and targeted treatment strategies.
| Characteristics | Values |
|---|---|
| Gram Stain | Positive |
| Cell Shape | Rod (Bacillus) |
| Spore Formation | Negative (Not all Gram-positive rods form spores) |
| Examples | Listeria monocytogenes, Corynebacterium species, Erysipelothrix rhusiopathiae |
| Cell Wall Structure | Thick peptidoglycan layer, teichoic acids present |
| Common Habitats | Soil, water, food, human and animal microbiota |
| Pathogenicity | Varies; some are pathogenic (e.g., Listeria), others are commensal or saprophytic |
| Metabolism | Diverse; can be aerobic, anaerobic, or facultative anaerobic |
| Antibiotic Susceptibility | Generally susceptible to penicillins, cephalosporins, and vancomycin, but resistance can occur |
| Clinical Significance | Infections can range from mild (e.g., skin infections) to severe (e.g., listeriosis, diphtheria-like illnesses) |
| Identification Methods | Gram staining, culture, biochemical tests, molecular methods (e.g., PCR) |
| Sporulation Ability | Absent in spore-negative species; spores are not formed under any conditions |
| Environmental Survival | Varies; spore-negative species may be less resilient in harsh conditions compared to spore-forming counterparts |
Explore related products
What You'll Learn
- Bacillus vs. Non-Bacillus Rods: Differentiating spore-forming Bacillus from non-spore-forming gram-positive rods like Listeria
- Spore Staining Techniques: Methods to confirm spore presence in gram-positive rods accurately
- Clinical Significance: Impact of spore status on infection treatment and patient outcomes
- Environmental Factors: How conditions influence spore formation in gram-positive rods
- Identification Challenges: Common pitfalls in classifying spore-negative gram-positive rods

Bacillus vs. Non-Bacillus Rods: Differentiating spore-forming Bacillus from non-spore-forming gram-positive rods like Listeria
Gram-positive rods are a diverse group of bacteria, but not all are created equal. While *Bacillus* species are renowned for their spore-forming abilities, other gram-positive rods, like *Listeria monocytogenes*, lack this survival mechanism. This distinction is critical in clinical and industrial settings, where misidentification can lead to inappropriate treatment or contamination. For instance, *Bacillus* spores can survive extreme conditions, including heat and desiccation, whereas *Listeria* relies on its ability to grow at refrigeration temperatures for persistence. Understanding these differences is essential for targeted interventions.
To differentiate *Bacillus* from non-spore-forming gram-positive rods like *Listeria*, start with a simple heat treatment. Expose the bacteria to 80°C for 10 minutes—*Bacillus* spores will survive, while *Listeria* cells will be inactivated. Follow this with a Gram stain and microscopy: both will appear as gram-positive rods, but *Bacillus* often shows oval, refractile spores under phase-contrast microscopy. For confirmation, perform a sporulation assay by culturing in nutrient broth and observing spore formation over 48 hours. *Bacillus* will produce spores, while *Listeria* will not.
From a clinical perspective, the ability to form spores makes *Bacillus* a formidable pathogen, particularly in immunocompromised individuals. For example, *Bacillus anthracis* causes anthrax, a disease treatable with antibiotics like ciprofloxacin (500 mg every 12 hours for adults) if diagnosed early. In contrast, *Listeria* infections, such as listeriosis, are treated with ampicillin (2 g every 4 hours) and gentamicin (1 mg/kg every 8 hours) for synergistic effect. Misidentifying these organisms could lead to ineffective therapy, emphasizing the need for accurate differentiation.
In food safety, the spore-forming nature of *Bacillus* poses a unique challenge. Spores can survive pasteurization (72°C for 15 seconds), necessitating more stringent processes like ultra-high temperature (UHT) treatment. *Listeria*, however, is controlled through refrigeration and proper sanitation, as it does not form spores. For example, ready-to-eat foods should be stored below 4°C to inhibit *Listeria* growth. Cross-contamination between these bacteria in food processing facilities can lead to outbreaks, highlighting the importance of species-specific control measures.
In summary, while both *Bacillus* and non-spore-forming gram-positive rods like *Listeria* share gram-positive cell wall characteristics, their spore-forming abilities dictate distinct survival strategies and control methods. Clinicians and food safety professionals must employ targeted tests, such as heat resistance assays and microscopy, to differentiate these organisms accurately. This precision ensures effective treatment and prevention, safeguarding both health and industry standards.
Dormant Mold Spores: Hidden Health Risks and Safety Concerns
You may want to see also

Spore Staining Techniques: Methods to confirm spore presence in gram-positive rods accurately
Gram-positive rods, such as *Bacillus* and *Clostridium* species, are often associated with spore formation, a survival mechanism that allows them to withstand harsh environmental conditions. However, not all gram-positive rods produce spores, making accurate identification crucial for clinical and laboratory purposes. Spore staining techniques serve as a definitive method to confirm spore presence, distinguishing spore-forming from non-spore-forming bacteria. These techniques rely on the unique properties of spores, which are highly resistant to heat, chemicals, and dyes, enabling their visualization under a microscope.
One widely used method is the endospore staining technique, which employs a combination of primary and secondary stains to differentiate spores from vegetative cells. The process begins with heating the bacterial smear, a step known as heat fixation, which helps to adhere the bacteria to the slide and enhance spore resistance. Following this, the smear is treated with a primary stain, typically malachite green, which penetrates the spore’s impermeable outer coat due to the application of heat. After rinsing, a counterstain such as safranin is applied to color the vegetative cells, leaving the spores as distinct green bodies against a pink background. This method is highly specific and allows for clear visualization of spores, even in mixed cultures.
An alternative technique is the Wurtz-Monneret staining method, which uses a combination of nigrosin and malachite green to stain spores. In this method, the bacterial smear is first treated with nigrosin, a water-soluble dye that imparts a dark background. Malachite green is then applied, staining the spores green. The contrast between the dark background and the brightly stained spores enhances their visibility. This method is particularly useful for identifying spores in environmental samples, where the presence of debris or other microorganisms can complicate analysis.
For laboratories seeking a simpler approach, the Schaeffer-Fulton staining method offers a straightforward protocol. This technique involves staining the bacterial smear with malachite green for 5 minutes, followed by rinsing and counterstaining with safranin for 1 minute. The key to success lies in maintaining the heat fixation step, typically performed by passing the slide through a flame 3–4 times. This ensures that the malachite green penetrates the spore’s outer layer effectively. The result is a clear differentiation between spores (green) and vegetative cells (red), making it an ideal choice for routine diagnostic work.
While these techniques are highly effective, certain precautions must be observed to ensure accurate results. Overheating during the fixation step can distort bacterial morphology, while insufficient heating may prevent malachite green from penetrating the spore. Additionally, the quality of reagents and the timing of staining steps are critical. For instance, using old or contaminated malachite green can lead to poor spore staining, while prolonged exposure to safranin may obscure the spores. Adhering to standardized protocols and performing positive and negative controls can mitigate these risks, ensuring reliable confirmation of spore presence in gram-positive rods.
Mastering Mushroom Spore Harvesting: A Step-by-Step Guide for Beginners
You may want to see also

Clinical Significance: Impact of spore status on infection treatment and patient outcomes
Gram-positive rods, whether spore-forming or not, present distinct challenges in clinical settings. Spore-forming species, such as *Clostridium difficile* and *Bacillus anthracis*, are notorious for their resilience, surviving harsh conditions like heat, desiccation, and antibiotics. This resilience complicates treatment, as spores require specific antimicrobial agents (e.g., metronidazole, vancomycin, or fidaxomicin for *C. difficile*) and often necessitate prolonged therapy. Non-spore-forming gram-positive rods, like *Listeria monocytogenes*, are more susceptible to standard antibiotics but can still cause severe infections, particularly in immunocompromised patients or pregnant individuals. Understanding spore status is critical for tailoring treatment strategies and improving patient outcomes.
Consider a patient with a suspected *C. difficile* infection (CDI). The spore-forming nature of this pathogen means that standard antibiotics may not eradicate the infection, and in fact, broad-spectrum antibiotics often precipitate CDI by disrupting gut flora. Treatment must target both vegetative cells and spores, typically with oral vancomycin (125 mg every 6 hours) or fidaxomicin (200 mg twice daily). Failure to account for spore status can lead to recurrent infections, which occur in up to 35% of cases. In contrast, a *Listeria* infection in a pregnant woman requires prompt treatment with ampicillin (2 g every 4 hours) plus gentamicin, as spores are not a concern, but delayed therapy can lead to fetal loss or neonatal sepsis.
The impact of spore status extends beyond antibiotic selection to infection control practices. Spore-forming bacteria require stringent disinfection protocols, such as the use of sporicidal agents like bleach (5,000–10,000 ppm) for environmental decontamination. Healthcare facilities must implement isolation precautions for patients with spore-forming infections, such as CDI, to prevent transmission. Non-spore-forming pathogens, while easier to eradicate, still require standard precautions but do not necessitate the same level of environmental control. For instance, *Listeria* outbreaks in food facilities are managed through sanitation practices targeting vegetative cells, not spores.
Patient outcomes are significantly influenced by the timely identification of spore status. Misdiagnosis or delayed treatment of spore-forming infections can lead to complications like pseudomembranous colitis in CDI or systemic anthrax in *B. anthracis* cases. For non-spore-forming infections, such as listeriosis, early diagnosis and treatment are critical, especially in high-risk groups like the elderly or neonates. Prognosis improves dramatically with appropriate therapy, but delays can result in sepsis, meningitis, or death. Clinicians must remain vigilant, particularly in patients with a history of antibiotic use or exposure to contaminated food or environments.
In summary, spore status is a pivotal determinant in the management of gram-positive rod infections. It dictates antibiotic choice, treatment duration, infection control measures, and patient outcomes. Clinicians must differentiate between spore-forming and non-spore-forming pathogens to implement effective strategies, from prescribing sporicidal antibiotics to enforcing rigorous disinfection protocols. By addressing spore status proactively, healthcare providers can mitigate the risks associated with these infections and improve patient recovery rates.
Are Spores and Endospores Identical? Unraveling the Microbial Differences
You may want to see also
Explore related products
$22.96 $27.61

Environmental Factors: How conditions influence spore formation in gram-positive rods
Spore formation in gram-positive rods is not a random event but a highly regulated process triggered by specific environmental cues. These bacteria, such as *Bacillus* and *Clostridium* species, have evolved to sense and respond to changes in their surroundings, ensuring survival under harsh conditions. The decision to form spores is a last resort, activated when nutrients become scarce, oxygen levels drop, or other stressors threaten cellular integrity. Understanding these triggers is crucial for both scientific research and practical applications, from food preservation to medical treatments.
Consider the role of nutrient deprivation, a primary environmental factor driving spore formation. When essential nutrients like carbon, nitrogen, or phosphorus are depleted, gram-positive rods initiate a signaling cascade that redirects metabolic resources toward sporulation. For instance, in *Bacillus subtilis*, the depletion of amino acids triggers the activation of the master regulator Spo0A, which orchestrates the sporulation process. In laboratory settings, researchers often induce sporulation by transferring cells to nutrient-poor media, such as DSM (Difco Sporulation Medium), where spore formation typically peaks within 24–48 hours. This controlled environment mimics the natural stress conditions that bacteria encounter in soil or decaying organic matter.
Temperature and pH also play significant roles in modulating spore formation. Optimal sporulation in *Bacillus* species occurs at temperatures between 30°C and 37°C, with deviations from this range either delaying or inhibiting the process. For example, exposure to temperatures above 45°C can trigger heat shock responses that compete with sporulation pathways. Similarly, extreme pH levels—either highly acidic or alkaline—can disrupt the delicate balance of cellular processes required for spore development. In industrial applications, such as food processing, controlling these parameters is essential to either promote or prevent sporulation, depending on the desired outcome.
Oxygen availability is another critical factor influencing spore formation in gram-positive rods. Many of these bacteria are facultative anaerobes, capable of switching between aerobic and anaerobic metabolism. Under low-oxygen conditions, such as those found in deep soil layers or within the gut microbiome, sporulation is often favored as a survival strategy. For instance, *Clostridium botulinum* forms spores in anaerobic environments, which can later germinate and produce toxins under favorable conditions. Practical tips for managing oxygen levels include using sealed containers or anaerobic chambers in laboratory experiments to simulate these conditions accurately.
Finally, the presence of certain chemicals or antimicrobial agents can either inhibit or enhance spore formation. For example, sub-lethal concentrations of antibiotics like penicillin or rifampicin can induce sporulation in some gram-positive rods by mimicking nutrient stress. Conversely, agents that disrupt cell wall synthesis or DNA replication, such as lysozyme or UV radiation, can halt the sporulation process altogether. In clinical settings, understanding these interactions is vital for developing strategies to control spore-forming pathogens, such as *Clostridioides difficile*, which can cause severe infections in healthcare environments.
By manipulating these environmental factors, scientists and practitioners can either encourage or suppress spore formation in gram-positive rods, depending on their goals. Whether in the lab, the clinic, or the food industry, this knowledge provides a powerful tool for managing these resilient bacteria and their impact on human health and safety.
Can You Use Bonemeal on Spore Blossoms? A Minecraft Guide
You may want to see also

Identification Challenges: Common pitfalls in classifying spore-negative gram-positive rods
Gram-positive rods are a diverse group of bacteria, and their classification can be particularly challenging when it comes to determining spore formation. While many gram-positive rods are spore-formers, such as *Bacillus* and *Clostridium* species, a significant number are spore-negative. Misidentification often arises from over-reliance on morphological characteristics or incomplete testing, leading to diagnostic errors with clinical implications. For instance, mistaking a spore-negative rod like *Listeria monocytogenes* for a spore-forming *Bacillus* species can delay appropriate treatment, as *Listeria* requires specific antibiotics like ampicillin.
One common pitfall is the assumption that all gram-positive rods are spore-formers, especially when using traditional staining methods. The Gram stain, while essential, does not differentiate between spore-positive and spore-negative organisms. Technicians may misinterpret the presence of a thick, refractile cell wall in some spore-negative rods, such as *Corynebacterium* species, as indicative of spore formation. To avoid this, laboratories should incorporate additional tests like the spore stain (using heat and malachite green) to confirm spore presence. Without this step, misclassification can lead to inappropriate patient management, particularly in immunocompromised individuals where *Listeria* infections are more severe.
Another challenge lies in the phenotypic similarities between spore-negative and spore-positive rods. For example, both *Listeria* and *Bacillus* species are catalase-positive and can grow in similar environments. However, *Listeria* is beta-hemolytic on blood agar, while *Bacillus* is not. Failure to perform hemolysis tests or misinterpretation of colony morphology can result in misidentification. Clinicians and microbiologists must be vigilant in correlating biochemical test results with clinical context, such as the patient’s symptoms and exposure history, to ensure accurate identification.
Practical tips for accurate classification include using selective media like PALCAM agar for *Listeria* isolation and incorporating molecular methods such as PCR for rapid identification. Additionally, maintaining a high index of suspicion for spore-negative rods in cases of meningitis, sepsis, or foodborne illness is crucial. For example, *Listeria* is a leading cause of foodborne bacterial infections in pregnant women and the elderly, with a mortality rate of up to 30% in severe cases. Early recognition through precise identification can significantly improve outcomes.
In conclusion, classifying spore-negative gram-positive rods requires a multifaceted approach that goes beyond basic staining techniques. By avoiding common pitfalls, such as morphological assumptions and incomplete testing, and by leveraging advanced diagnostic tools, laboratories can enhance accuracy and support effective clinical management. This precision is particularly vital in high-risk populations, where timely identification of pathogens like *Listeria* can be life-saving.
Discovering Timmask Spores: Top Locations for Rare Fungal Finds
You may want to see also
Frequently asked questions
Yes, not all Gram-positive rods produce spores. While some, like *Bacillus* and *Clostridium*, are spore-forming, others such as *Listeria monocytogenes* and *Corynebacterium* are spore-negative.
Spore-negative Gram-positive rods can be identified through staining techniques like the Schaeffer-Fulton stain, which will not show spores, or by observing their inability to survive extreme conditions that typically require spore formation.
Not necessarily. Pathogenicity depends on the specific organism and its virulence factors, not just spore formation. For example, *Listeria monocytogenes* (spore-negative) can cause severe infections like listeriosis.
Common examples include *Listeria monocytogenes*, *Corynebacterium* species, *Lactobacillus*, and *Propionibacterium*. These organisms do not form spores as part of their life cycle.





















![Liquid Alive Enzyme Producing Bacteria-Odor Digest 1 GAL [Set of 2]](https://m.media-amazon.com/images/I/612n9OlHSFL._AC_UL320_.jpg)



